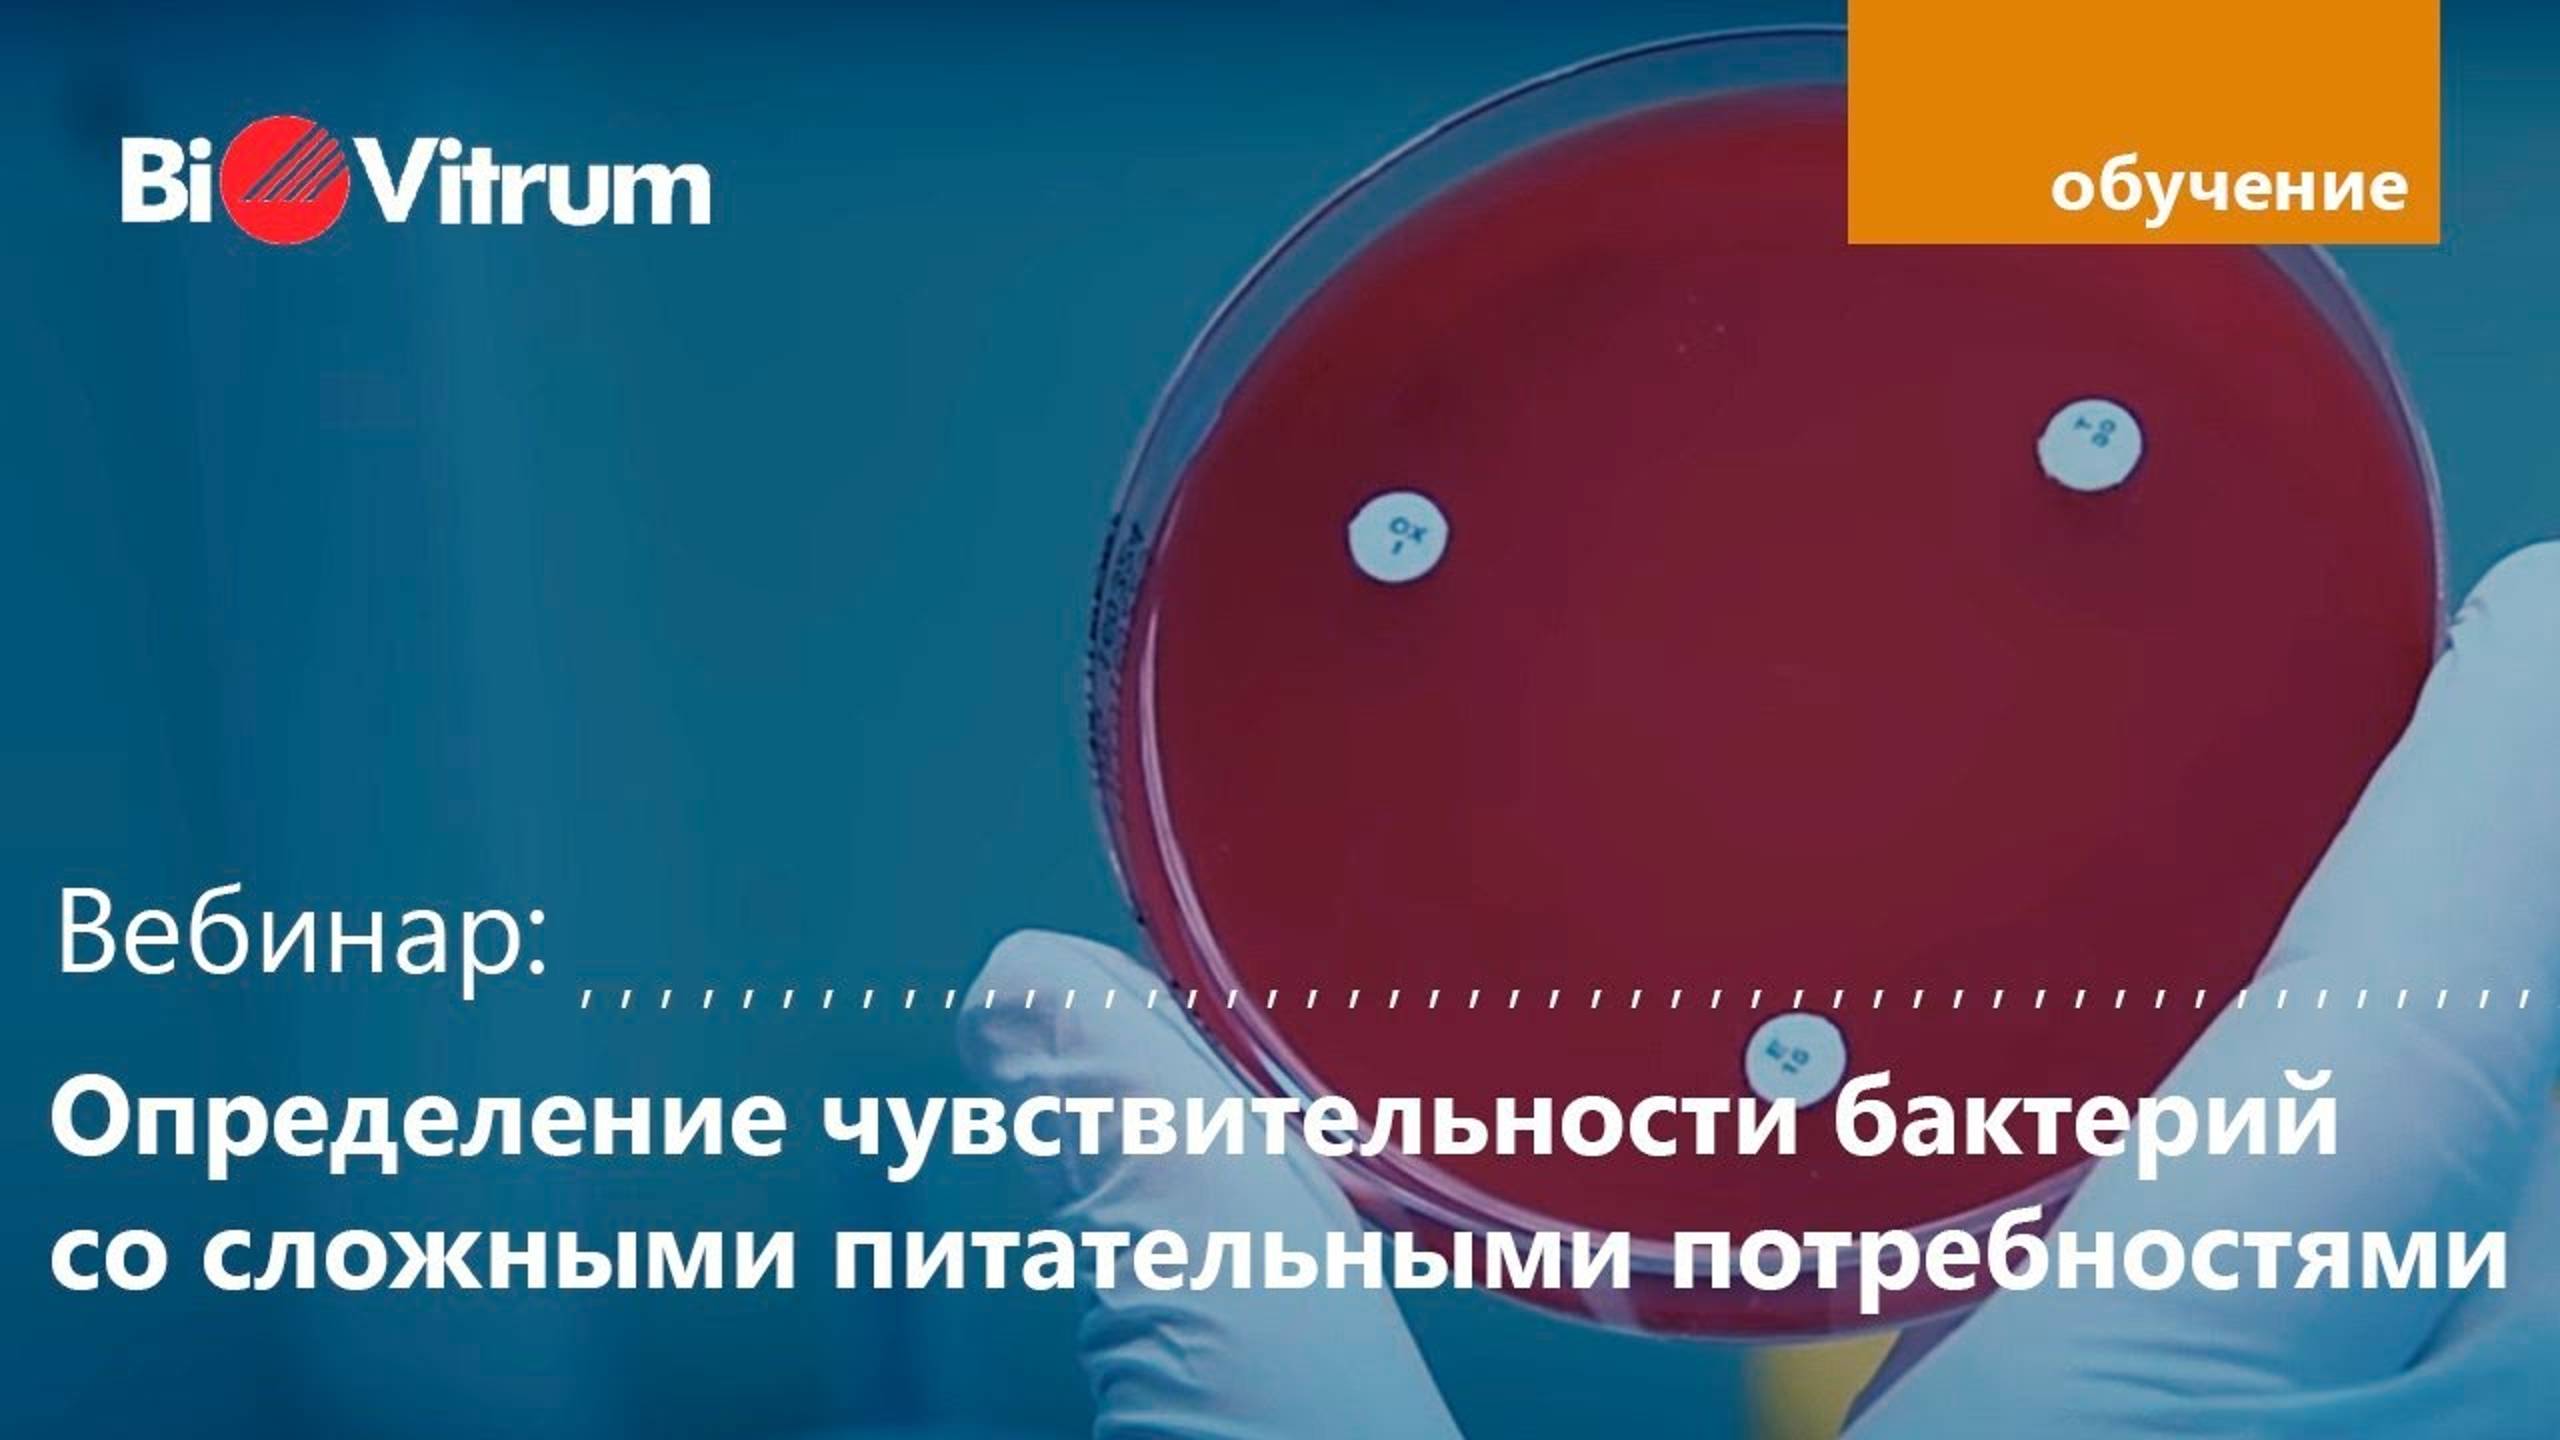

- Лайфстайл
- Недвижимость
- Здоровье
- Природа
- Дизайн
- Техника и оборудование
- Бизнес и предпринимательство
- Искусство
- Религия
- Строительство и ремонт
- Сад и огород
- Аудиокниги
- Кулинария
- Интервью
- Развлечения
- Лайфхаки
- Эзотерика
- Охота и рыбалка
- Наука
- Политика
- Психология
- Аудио
- Технологии и интернет
- Красота
- Телепередачи
- Детям
- Аниме
- Хобби
- Видеоигры
- Юмор
- Образование
- Спорт
- Разное
- Путешествия
- Животные
- Новости и СМИ
- Мультфильмы
- Музыка
- Сериалы
- Фильмы
- Авто-мото
Рост эффективности лаборатории
Семинар для лаборантов-гистологов «Пути повышения эффективности работы гистологической лаборатории». Мероприятие состоялось 13 ноября 2021 года в Краснодаре.
Семинар организован под эгидой ГБУЗ «Научно -исследовательский институт — Краевая Клиническая больница №1 им. проф. С.В. Очаповского».
Лекции:
«Состояние патолого-анатомической службы в регионе» Понкина О.Н.
«Правила транспортировки и фиксации материала для патолого-анатомических исследований. Примеры СОПов». Воловик К.
«Правила проводки и заливки материала в процессе пробоподготовки блоков. Примеры СОПов». Воловик К.
«Контроль качества выполнения Гистологической пробоподготовки: суть, подходы, основные практики». Разварина Е.
«Гистологические красители: какие и для каких целей». Пойкелус О.
«Важные этапы пробоподготовки для молекулярных методов исследований». Ермаченкова Т.
«Пробоподготовка для молекулярных методов исследований». Аникаев А. Ю.
«Нормативно-правовая база работы ПАО». Воловик К.
• Продукция для гистологии в каталоге “БиоВитрум”: https://biovitrum.ru/catalog/histology/
• Читайте полезные советы для гистологов в нашей группе ВКонтакте: https://vk.com/histoclub
• Присоединяйтесь к сообществу “Гистоклаб” на Facebook: https://www.facebook.com/histoclubru
• Больше видео по гистопроцессу - в плей-листе: https://www.youtube.com/playlist?list=PLMKCvK7i_qNTggRHMbbhIW
Видео Рост эффективности лаборатории автора БиоВитрум
Видео Рост эффективности лаборатории автора БиоВитрум
Информация
27 ноября 2024 г. 14:56:17
04:31:49
Похожие видео

![Lecture 3.12 - Image Filtering [Box Filter]](http://pic.rutubelist.ru/video/2024-11-27/f6/9d/f69d46250fe46872fd941a3b3a068741.jpg?size=s)

![Lecture 3.15 - Image Filtering [Introduction to Image Derivatives]](http://pic.rutubelist.ru/video/2024-11-27/76/e7/76e73f096e43a73b18d5d662fdbedd9b.jpg?size=s)









![Lecture 2.1 Linear Algebra Basics [Vectors]](http://pic.rutubelist.ru/video/2024-11-27/8f/dd/8fddc1e9b60c990c99c361346a137318.jpg?size=s)

